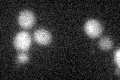

View description
One of two type V myosin motors (along with MYO2) involved in actin-based transport of cargos; required for mRNA transport, including ASH1 mRNA, and facilitating the growth and movement of ER tubules into the growing bud along with She3p
Localization:
Intensity:
Fold change:
Significance:
-
C’ GFP library in SD

below threshold15.81 -
N' NOP1pr-GFP in SD

N/A0 -
N' TEF2pr-mCherry in SD

N/A0 -
N' NATIVEpr-GFP in SD

N/A0 -
N' TEF2pr-VC and Cyto-VN in SD

N/A0 -
C’ GFP library in SD+DTT
cytosol14.270.9No -
C’ GFP library in SD+H2O2

cytosol19.271.21No -
C’ GFP library in Starvation Media

cytosol17.21.08No -
C’ GFP library on the background of Pup2-DaMP

below threshold -
C’ GFP library on the background of CCT mutant

below threshold17.1121.08191No
